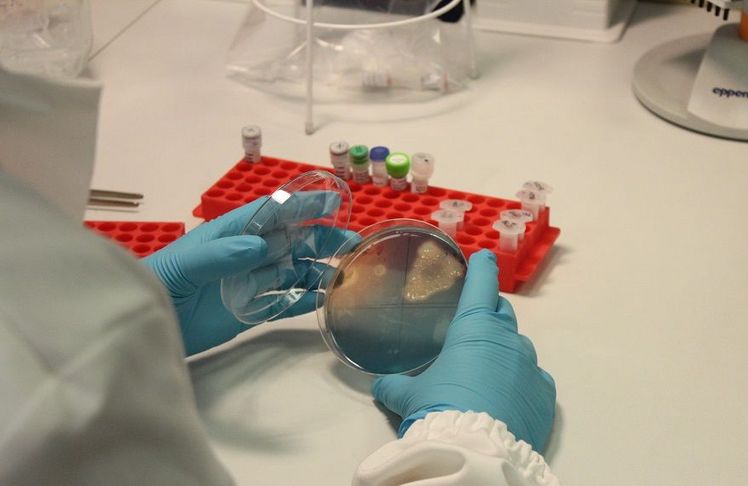
Mikrobiologische Analysen im Labor für Molekularbiologie. Bild: Versuchszentrum Laimburg. Mikrobiologische Analysen im Labor für Molekularbiologie. Bild: Versuchszentrum Laimburg.

- Startseite
- Mehr...
- Dossiers
- Krieg in der Ukraine
- Im Interview: Katrin Janik
Im Interview: Katrin Janik
Am Versuchszentrum Laimburg leitet Katrin Janik die Arbeitsgruppe „Funktionelle Genomik“ und den Fachbereich „Molekular- und Mikrobiologie“. Die Wissenschaftlerinnen und Wissenschaftler untersuchen die molekulare Funktion von Genen unterschiedlicher Organismen wie z.B. Pflanzen und Bakterien. Im Mittelpunkt der Arbeiten stehen Bakterien und Pflanzen, die eine wirtschaftliche Bedeutung für die Südtiroler Landwirtschaft haben. Insbesondere wird an der Apfeltriebsucht geforscht: Eine bakterielle Infektionskrankheit des Apfelbaums, die durch Phytoplasmen ausgelöst wird und in Südtirol seit über 20 Jahren zu großen wirtschaftlichen Schäden im Apfelanbau führt.
Katrin Janik erzählt mehr über Phytoplasmen und das Projekt „FIGHToplasma“, das von der Freien Universität Bozen zusammen mit dem Versuchszentrum Laimburg durchgeführt wird.
Frau Janik, beginnen wir am Anfang: Was sind Phytoplasmen und warum ist die Erforschung ihrer Biologie wichtig?
Phytoplasmen sind eine Gruppe bakterieller Organismen ohne Zellwand, die nur innerhalb ihrer Pflanzen- oder Insektenwirte überleben können. Sie werden von Insekten übertragen, wie beispielsweise dem Sommerapfelblattsauger[JK1] (Cacopsylla picta) und dem Weißdornblattsauger (Cacopsylla melanoneura) und können im Apfelanbau zu großen Schäden führen. Ein infizierter Baum produziert Früchte minderer Qualität und stellt ein hohes Infektionsrisiko für weitere Bäume dar. Derzeit zielen die einzigen verfügbaren Bekämpfungsmaßnahmen darauf ab, die Ausbreitung der Krankheit einzudämmen, indem die Überträgerinsekten bekämpft sowie infizierte Bäume aus den Anlagen entfernt werden. Spezifische Bekämpfungsmöglichkeiten gegen die Phytoplasmen, die sich für den großflächigen Einsatz im Feld eignen, gibt es bisher nicht. Phytoplasmen interagieren mit ihren Insekten- und Pflanzenwirten in einer sehr komplexen Art und Weise. Sie manipulieren die Pflanze zu ihren Gunsten und beeinflussen die Attraktivität infizierter Bäume gegenüber den Überträger-Insekten. Die molekularen Grundlagen dieser Interaktionen sind noch nicht im Detail bekannt.
Die Apfeltriebsucht hat große Auswirkungen auf den Apfelanbau. Dennoch ist das Wissen über die Ursachen noch immer gering, und bisher besteht die einzige Lösung darin, die infizierten Bäume zu roden. Warum wissen wir noch immer so wenig?
Die Forschung an der Apfeltriebsucht gestaltet sich als sehr kompliziert, unter anderem weil sich Phytoplasmen nicht außerhalb ihrer Insekten- oder Pflanzenwirte kultivieren lassen. Auch die Zucht der Vektorinsekten gestaltet sich schwierig. Das komplexe Zusammenspiel zwischen Bakterium, Pflanze und Überträgerinsekt führt dazu, dass viele Faktoren die Krankheitsverbreitung beeinflussen. Die wissenschaftliche Aufklärung der molekularen Mechanismen und ein besseres Verständnis der Krankheits- und Symptomentwicklung in der Pflanze gehören zu einer der wichtigsten Strategien, um zukünftig maßgeschneiderte Bekämpfungsmöglichkeiten zu entwickeln. In den letzten Jahren konnten wir am Versuchszentrum Laimburg bereits wichtige Erkenntnisse gewinnen, welche molekularen Mechanismen eine Rolle bei der Krankheitsentwicklung in der Pflanze spielen.
Die Apfeltriebsucht ist eine in den 1950er Jahren entdeckte Phytopathologie. Seit dem Jahr 2000 scheint sie zuzunehmen, wobei Südtirol zu den am stärksten betroffenen Gebieten gehört. Welche sind die Gründe für diese Ausbreitung?
Die Ausbreitung der Apfeltriebsucht hängt maßgeblich von der Verbreitung der Überträgerinsekten ab. Ein starker Befallsdruck konnte in der Vergangenheit häufig mit dem verstärkten Auftreten der Insekten in Verbindung gebracht werden. Eine Vernachlässigung der Rodungspflicht kann ebenfalls dazu beitragen, dass sich die Krankheit ausbreitet.
Wie wurde das Projekt „FIGHToplasma” geboren und wer sind die Protagonisten?
Der Apfeltriebsuchterreger wird in Südtirol von zwei Blattsaugern übertragen, vorwiegend Cacopsylla picta, aber auch von Cacopsylla melanoneura, einem weniger effizienter Überträger, zu dessen Rolle in der Ausbreitung der Krankheit noch viele Fragen offen sind. Gibt es Untergruppen dieses Insektes, die wesentlich bessere Überträger sind als andere? Kann die Fähigkeit, die Krankheit zu übertragen, auf bestimmte genetische Merkmale der Vektorinsekten oder auf das Vorhandensein bestimmter Mikroorganismen in ihrem Darm zurückzuführen sein? Gibt es Stämme von Phytoplasmen, die sich besser für von Cacopsylla melanoneura übertragen lassen als andere? Im Projekt „FIGHToplasma“ arbeiten wir nun gemeinsam mit Kolleginnen und Kollegen der Universität für Bodenkultur Wien und unter der Leitung der Freien Universität Bozen an den komplexen Fragestellungen.
Wenn diese Forschung uns hilft, mehr über die Biologie der Überträgerinsekten zu erfahren, wie können wir diese neuen Informationen nutzen?
In diesem Projekt untersuchen wir bestimmte Faktoren genauer, die im Zusammenhang mit der Übertragungseffizienz der Insekten stehen. Die Ergebnisse dienen dazu Vorhersagen zur Übertragung und das Auftreten möglicher Befalls-Wellen zu machen. Die Ergebnisse werden auch tiefergehende Erkenntnisse über die molekulare Interaktion zwischen Phytoplasmen und Insekten liefern.
Vielen Dank!

Kommentare (0)
Bisher sind keine Kommentare zu diesem Artikel erstellt worden.